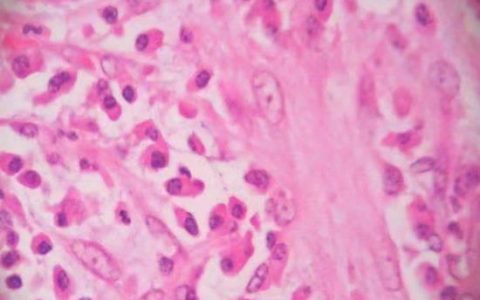
每日一题_2023.09.06

A 23-year old woman presents to the physician with a chief complaint of an excruciating, sharp pain in her right upper quadrant and fever. Complete physical examination is performed. Pelvic exam reveals bilateral adnexal and cervical motion tenderness and purulent discharge. Other laboratory studies reveal: WBC count: 14,200/mm3 Amylase: 28 U/L;Aspartate aminotransferase: 19 U/L Alanine;aminotransferase: 17 U/L Alkaline phosphatase: 23 U/L Hepatitis A IgG antibody: positive;Which of the following is the most likely diagnosis?
一名23岁女性因右上腹剧烈剧痛和发热就诊。进行全面的体格检查。盆腔检查显示双侧附件和颈部活动压痛和脓性分泌物。其他实验室检查显示:白细胞计数:14,200/mm3,淀粉酶:28 U/L,天冬氨酸氨基转移酶:19 U/L,丙氨酸氨基转移酶:17 U/L,碱性磷酸酶:23 U/L,甲型肝炎IgG抗体:阳性,以下哪一项是最可能的诊断?
(A) Acute cholecystitis 急性胆囊炎
(B) Chlamydial cervicitis 衣原体宫颈炎
(C) Fitz-Hugh-Curtis syndrome Fitz-Hugh-Curtis综合症
(D) Gonococcal urethritis 淋菌性尿道炎
(E) Hepatitis A 甲肝
(F) Tubo-ovarian abscess 卵管卵巢脓肿
答案解析:
肝周炎、Fitz – Hugh-Curtis综合症,出现在了25%的女性盆腔炎(PID)。PID是女性生殖道的一种上行性混合微生物感染,可累及子宫内膜、输卵管和/或腹腔。多达一半的PID病例由沙眼衣原体和淋病奈瑟菌引起。肝炎周围是一种并发症,通常表现为与PID症状相关的右上腹疼痛(典型的三联征是发热、腹痛和阴道分泌物)。在腹腔镜检查中,腹膜腔内会出现“小提琴弦”样粘连。
正确答案:C
原创文章(本站视频密码:66668888),作者:xujunzju,如若转载,请注明出处:https://zyicu.cn/?p=17366

 微信扫一扫
微信扫一扫  支付宝扫一扫
支付宝扫一扫